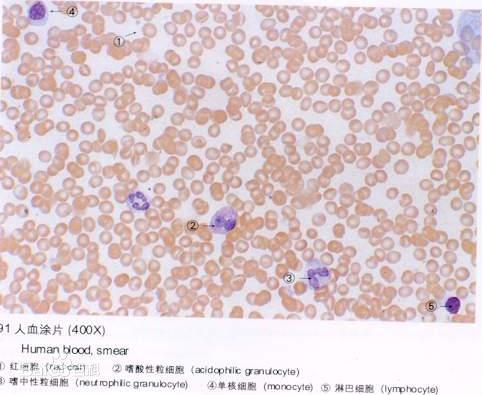
人体红细胞占人体细胞多少

人红细胞

原始红细胞 18
图片尺寸1080x810
输血|血管|骨髓|红细胞|血液_网易订阅
图片尺寸590x740
人的正常红细胞有多少?
图片尺寸600x428
【1805班贺严馨】血液中最多的血细胞——红细胞
图片尺寸1024x441
血涂片这些红细胞有什么不一样
图片尺寸1080x810
血红在静脉血红细胞照片
图片尺寸400x300
(2011泰州)依照你在显微镜下观察到的人血涂片中的成熟红细胞结构,用
图片尺寸184x206
小红细胞-实验诊断学-医学
图片尺寸888x664
这个片子染成这样是染色问题还是红细胞问题
图片尺寸1008x756
1右图是用显微镜观察的人血涂片放大图,据图回答: ⑴图中ppt
图片尺寸1080x810
人红细胞
图片尺寸1200x900
科学告诉你:如何从血液红细胞的形状看身体健康
图片尺寸640x422
问:今天上实验课的时候看了一下红细胞.
图片尺寸768x1024
所以红细胞非常重要,那么有些人红细胞偏低的原因是什么呢?
图片尺寸1020x600
正常红细胞
图片尺寸1200x919
血常规检查若这3个指标升高,注意:要引起警惕,别不当一回事|红细胞
图片尺寸620x529
红细胞携带氧分子
图片尺寸800x456
人体红细胞占人体细胞多少
图片尺寸482x395
已知正常人红细胞的含量为(3.5-5.5)×1012个/l,白细胞为(5-10)
图片尺寸439x166
红细胞
图片尺寸700x525